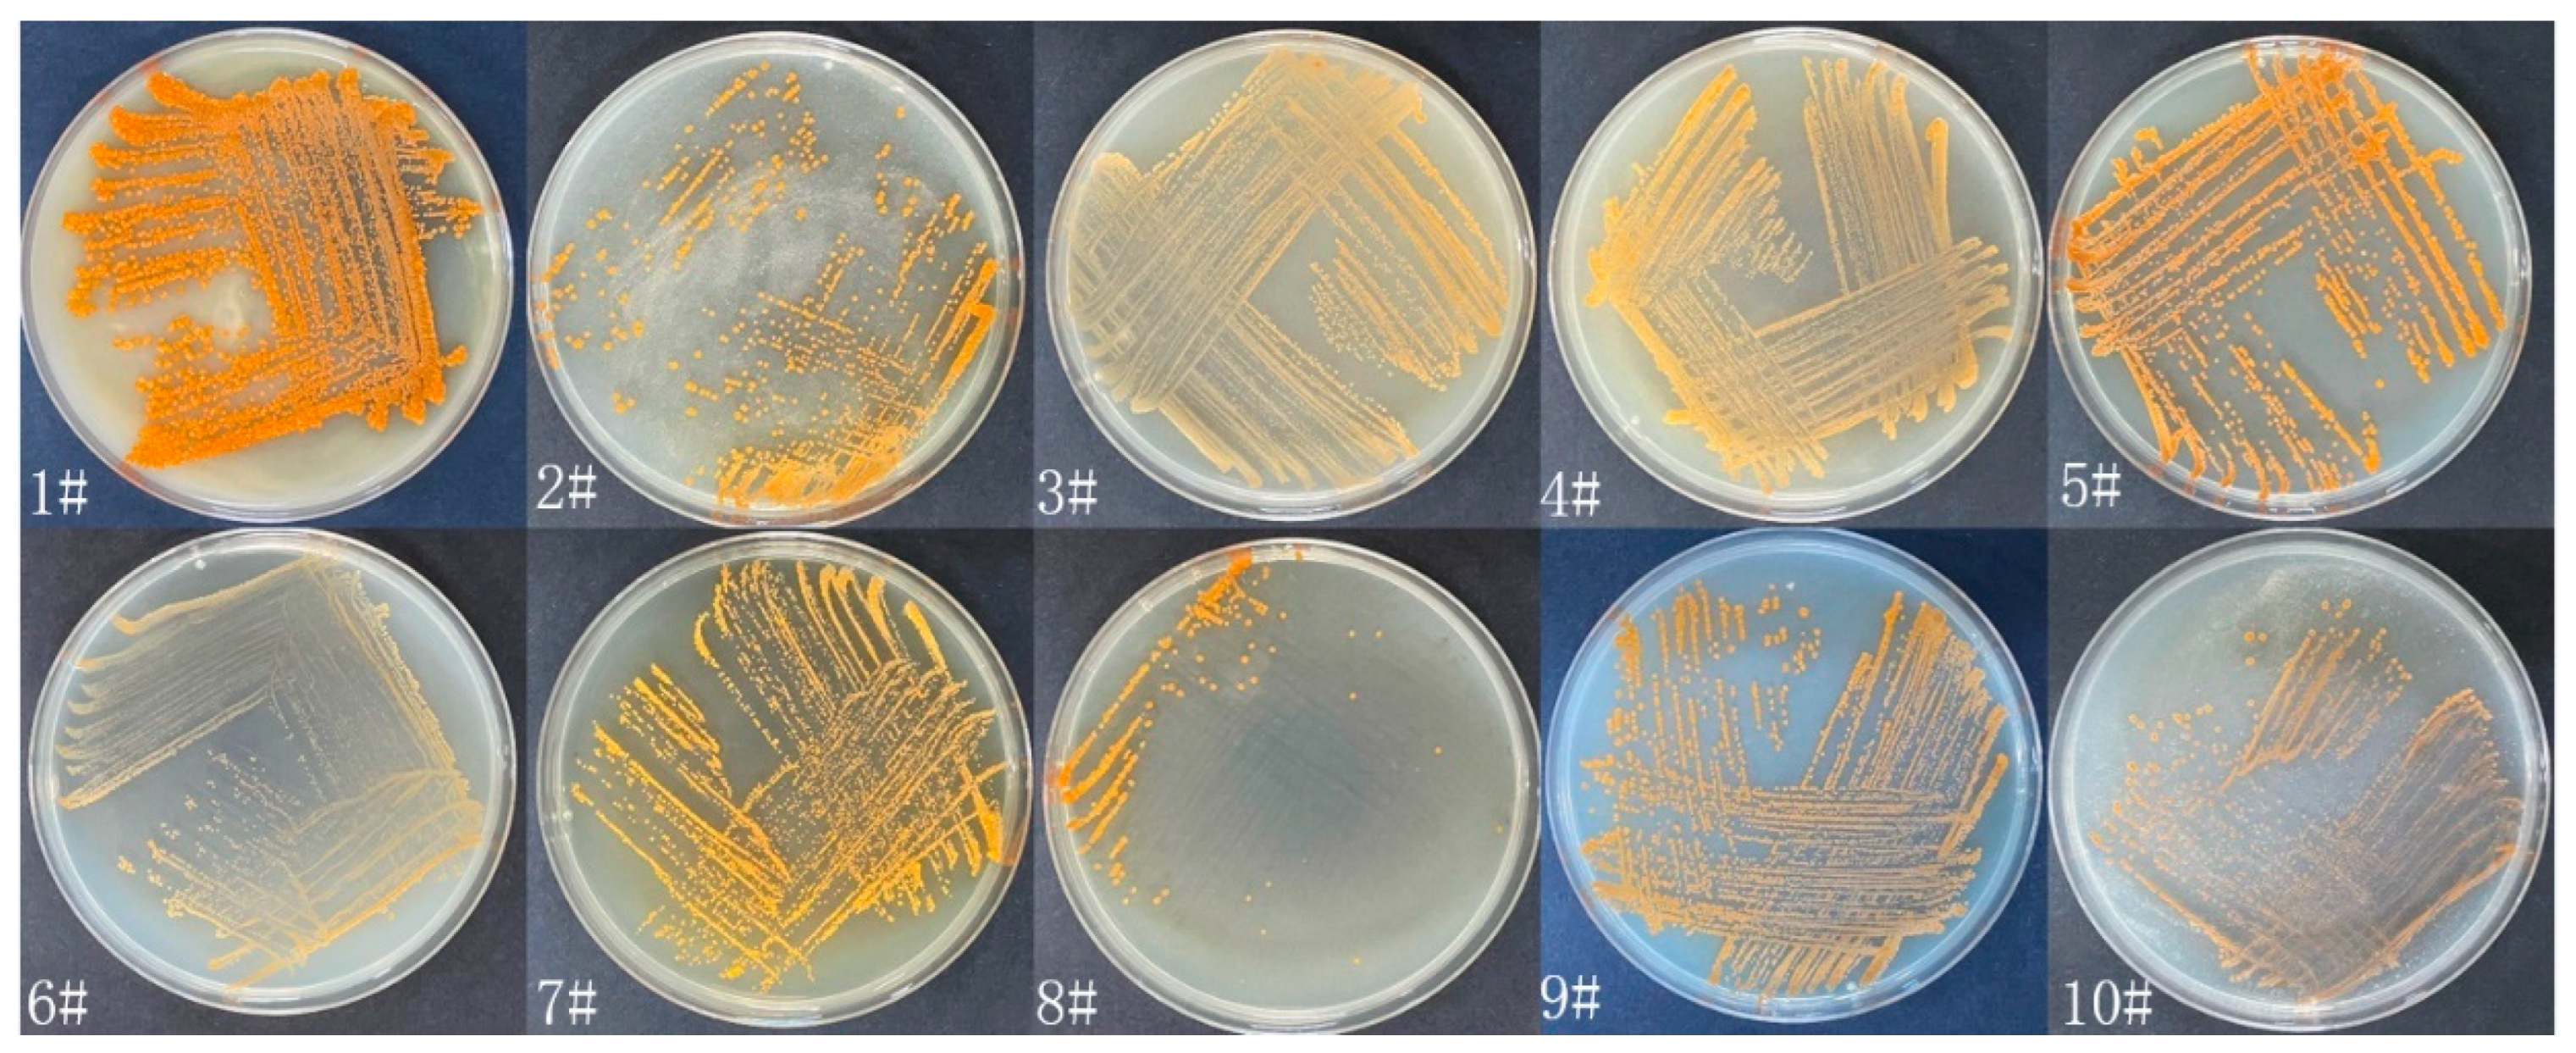
Microorganisms 10 02274 g001 Microorganisms 10 02274 g001

Nematicidal Metabolites from the Actinomycete Micromonospora sp. WH06
Abstract
1. Introduction
2. Materials and Methods
2.1. General Materials and Experimental Instruments
2.2. Media Formulations
2.3. Isolation and Activity Screening of Strains
2.4. Identification of Strain WH06
2.5. Fermentation of Strain WH06 and Isolation of Compounds
2.6. Nematicidal Activities of Isolated Metabolites
2.7. Test of Inhibitory Activity of Compounds on Egg Hatchings
3. Results
3.1. Isolation, Identification and Culture of Strain WH06
3.2. Structural Identification of Compounds
3.3. Nematicidal Activities of Compounds
3.4. Inhibitory Effects of Compounds on Egg Hatching
4. Discussion
Supplementary Materials
Author Contributions
Funding
Data Availability Statement
Acknowledgments
Conflicts of Interest
References
- Elling, A.A. Major emerging problems with minor Meloidogyne species. Phytopathology 2013, 103, 1092–1102. [Google Scholar] [CrossRef] [PubMed]
- Tapia-Vázquez, I.; Montoya-Martínez, A.C.; De los Santos-Villalobos, S.; Ek-Ramos, M.J.; Montesinos-Matías, R.; Martínez-Anaya, C. Root-Knot nematodes (Meloidogyne spp.) a threat to agriculture in Mexico: Biology, current control strategies, and perspectives. World J. Microbiol. Biotechnol. 2022, 38, 26. [Google Scholar] [CrossRef] [PubMed]
- Ruanpanun, P.; Tangchitsomkid, N.; Hyde, K.D.; Lumyong, S. Actinomycetes and fungi isolated from plant-parasitic nematode infested soils: Screening of the effective biocontrol potential, indole-3-acetic acid and siderophore production. World J. Microbiol. Biotechnol. 2010, 26, 1569–1578. [Google Scholar] [CrossRef]
- Shilpa; Sharma, P.; Thakur, V.; Sharma, A.; Rana, R.S.; Kumar, P. A status-quo review on management of root knot nematode in tomato. J. Hortic. Sci. Biotechnol. 2022, 97, 403–416. [Google Scholar] [CrossRef]
- Subbotin, S.A.; Palomares-Rius, J.E.; Castillo, P. Systematics of Root-Knot Nematodes (Nematoda: Meloidogynidae); Brill: Boston, MA, USA, 2021; Volume 14, ISBN 978-90-04-38758-4. [Google Scholar]
- Saad, A.M.; Salem, H.M.; El-Tahan, A.M.; El-Saadony, M.T.; Alotaibi, S.S.; El-Shehawi, A.M.; Abd El-Mageed, T.A.; Taha, A.E.; Alkahtani, M.A.; Ezzat Ahmed, A.; et al. Biological control: An effective approach against nematodes using black pepper plants (Piper nigrum L.). Saudi J. Biol. Sci. 2022, 29, 2047–2055. [Google Scholar] [CrossRef] [PubMed]
- Chen, J.; Li, Q.X.; Song, B. Chemical Nematicides: Recent research progress and outlook. J. Agric. Food Chem. 2020, 68, 12175–12188. [Google Scholar] [CrossRef] [PubMed]
- Ntalli, N.G.; Caboni, P. Botanical nematicides: A review. J. Agric. Food Chem. 2012, 60, 9929–9940. [Google Scholar] [CrossRef]
- Dong, L.Q.; Zhang, K.Q. Microbial control of plant-parasitic nematodes: A five-party interaction. Plant Soil. 2006, 288, 31–45. [Google Scholar] [CrossRef]
- Ahmad, G.; Khan, A.; Khan, A.A.; Ali, A.; Mohhamad, H.I. Biological control: A novel strategy for the control of the plant parasitic nematodes. Antonie Leeuwenhoek. 2021, 114, 885–912. [Google Scholar] [CrossRef]
- Khanna, K.; Kohli, S.K.; Ohri, P.; Bhardwaj, R. Plants-nematodes-microbes crosstalk within soil: A trade-off among friends or foes. Microbiol. Res. 2021, 248, 126755. [Google Scholar] [CrossRef]
- Pires, D.; Vicente, C.S.L.; Menéndez, E.; Faria, J.M.S.; Rusinque, L.; Camacho, M.J.; Inácio, M.L. The fight against plant-parasitic nematodes: Current status of bacterial and fungal biocontrol agents. Pathogens 2022, 11, 1178. [Google Scholar] [CrossRef] [PubMed]
- Kekuda, T.R.P.; Shobha, K.S.; Onkarappa, R. Fascinating diversity and potent biological activities of actinomycete metabolites. J. Pharm. Res. 2010, 3, 250–256. [Google Scholar]
- Solecka, J.; Zajko, J.; Postek, M.; Rajnisz, A. Biologically active secondary metabolites from actinomycetes. Open Life Sci. 2012, 7, 373–390. [Google Scholar] [CrossRef]
- Yan, S.; Zeng, M.; Wang, H.; Zhang, H. Micromonospora: A prolific source of bioactive secondary metabolites with therapeutic potential. J. Med. Chem. 2022, 65, 8735–8771. [Google Scholar] [CrossRef]
- Boumehira, A.Z.; El-Enshasy, H.A.; Hacène, H.; Elsayed, E.A.; Aziz, R.; Park, E.Y. Recent progress on the development of antibiotics from the genus Micromonospora. Biotechnol. Bioprocess Eng. 2016, 21, 199–223. [Google Scholar] [CrossRef]
- Sisi, Q.; Min, G.; Huanhuan, L.; Chunbo, Y.; Hongji, L.; Zheling, Z.; Peng, S. Secondary metabolites from marine Micromonospora. Chem. Biodivers. 2020, 17, e2000024. [Google Scholar]
- Wagman, G.H.; Testa, R.T.; Marquez, J.A.; Weinstein, M.J. Antibiotic G-418, a New Micromonospora-Produced Aminoglycoside with Activity Against Protozoa and Helminths: Fermentation, Isolation, and Preliminary Characterization. Antimicrob. Agents Chemother. 1974, 6, 144–149. [Google Scholar] [CrossRef]
- Abdelmohsen, U.R.; Szesny, M.; Othman, E.M.; Schirmeister, T.; Grond, S.; Stopper, H.; Hentschel, U. Antioxidant and anti-protease activities of diazepinomicin from the sponge-associated Micromonospora strain RV115. Mar. Drugs 2012, 10, 2208–2221. [Google Scholar] [CrossRef]
- Lee, Y.S.; Naning, K.W.; Nguyen, X.H.; Kim, S.B.; Moon, J.H.; Kim, K.Y. Ovicidal activity of lactic acid produced by Lysobacter capsici YS1215 on eggs of root-knot nematode, Meloidogyne incognita. J. Microbiol. Biotechnol. 2014, 24, 1510–1515. [Google Scholar] [CrossRef]
- Gao, C.; Gao, Z.; Greenway, F.L.; Burton, J.H.; Johnson, W.D.; Keenan, M.J.; Enright, F.M.; Martin, R.J.; Chu, Y.; Zheng, J. Oat consumption reduced intestinal fat deposition and improved health span in Caenorhabditis elegans model. Nutr. Res. 2015, 35, 834–843. [Google Scholar] [CrossRef]
- Hayakawa, M.; Sadakata, T.; Kajiura, T.; Nonomura, H. New methods for the highly selective isolation of Micromonospora and Microbispora from soil. J. Ferment. Bioeng. 1991, 72, 320–326. [Google Scholar] [CrossRef]
- Garcia, L.C.; Martínez-Molina, E.; Trujillo, M.E. Micromonospora pisi sp. nov., isolated from root nodules of Pisum sativum. Int. J. Syst. Evol. Microbiol. 2010, 60, 331–337. [Google Scholar] [CrossRef] [PubMed]
- Ntalli, N.G.; Ferrari, F.; Giannakou, I.; Menkissoglu-Spiroudi, U. Synergistic and antagonistic interactions of terpenes against Meloidogyne incognita and the nematicidal activity of essential oils from seven plants indigenous to Greece. Pest Manag. Sci. 2011, 67, 341–351. [Google Scholar] [CrossRef]
- Gutiérrez, M.; Capson, T.L.; Guzmán, H.M.; González, J.; Ortega-Barría, E.; Quiñoá, E.; Riguera, R. Antiplasmodial metabolites isolated from the marine octocoral Muricea austera. J. Nat. Prod. 2006, 69, 1379–1383. [Google Scholar] [CrossRef] [PubMed]
- Li, Y.; Li, X.F.; Kim, D.S.; Choi, H.D.; Son, B.W. Indolyl alkaloid derivatives, Nb-acetyltryptamine and oxaline from a marine-derived fungus. Arch. Pharm. Res. 2003, 26, 21–23. [Google Scholar] [CrossRef] [PubMed]
- Puszyńska-Tuszkanow, M.; Grabowski, T.; Daszkiewicz, M.; Wietrzyk, J.; Filip, B.; Maciejewska, G.; Cieślak-Golonka, M. Silver(I) complexes with hydantoins and allantoin. J. Inorg. Biochem. 2011, 105, 17–22. [Google Scholar] [CrossRef]
- Hideo, T.; Jingyu, C.; Machiko, M.; Manabu, K. The oxidation of alcohols in N-oxyl-immobilized silica gel/aqueous NaOCl disperse systems. A prominent access to a column-flow system. Bull. Chem. Soc. Jpn. 2004, 77, 1745–1755. [Google Scholar]
- Mehnaz, S.; Saleem, R.S.Z.; Yameen, B.; Pianet, I.; Schnakenburg, G.; Pietraszkiewicz, H.; Valeriote, F.; Josten, M.; Sahl, H.-G.; Franzblau, S.G.; et al. Lahorenoic acids A–C, ortho-dialkyl-substituted aromatic acids from the biocontrol strain Pseudomonas aurantiaca PB-St2. J. Nat. Prod. 2013, 76, 135–141. [Google Scholar] [CrossRef]
- Coursindel, T.; Restouin, A.; Dewynter, G.; Martinez, J.; Collette, Y.; Parrot, I. Stereoselective ring contraction of 2,5-diketopiperazines: An innovative approach to the synthesis of promising bioactive 5-membered scaffolds. Bioorg. Chem. 2010, 38, 210–217. [Google Scholar] [CrossRef]
- Driche, E.H.; Badji, B.; Bijani, C.; Belghit, S.; Pont, F.; Mathieu, F.; Zitouni, A. A new saharan strain of Streptomyces sp. GSB-11 produces maculosin and N-acetyltyramine active against multidrug-resistant pathogenic bacteria. Curr. Microbiol. 2022, 79, 29. [Google Scholar] [CrossRef]
- Sobolevskaya, M.P.; Denisenko, V.A.; Moiseenko, A.S.; Shevchenko, L.S.; Menzorova, N.I.; Sibirtsev, Y.T.; Kim, N.Y.; Kuznetsova, T.A. Bioactive metabolites of the marine actinobacterium Streptomyces sp. KMM 7210. Russ. Chem. Bull. 2007, 56, 838–840. [Google Scholar] [CrossRef]
- Meng, X.F.; Peng, J.; Gong, B.Y.; Zhu, B.Q. SIPI-94-1129-I (N-acetyltyramine), inhibitor of factor XIIIa from Actinopolyspora. Zhongguo Kangshengsu Zazhi. 1998, 4, 271–273. [Google Scholar]
- Ivanova, V.; Graefe, U.; Schlegel, R.; Schlegel, B.; Gusterova, A.; Kolarova, M.; Aleksieva, K. Isolation and structure elucidation of tyramine and indole alkaloids from Antarctic strain Microbispora aerata IMBAS-11A. Biotechnol. Biotechnol. Equip. 2003, 17, 128–133. [Google Scholar] [CrossRef]
- Zhang, W.; Wei, S.; Zhang, J.; Wu, W. Antibacterial activity composition of the fermentation broth of Streptomyces djakartensis NW35. Molecules 2013, 18, 2763–2768. [Google Scholar] [CrossRef]
- Ben Ameur Mehdi, R.; Shaaban, K.A.; Rebai, I.K.; Smaoui, S.; Bejar, S.; Mellouli, L. Five naturally bioactive molecules including two rhamnopyranoside derivatives isolated from the Streptomyces sp. strain TN58. Nat. Prod. Res. 2009, 23, 1095–1107. [Google Scholar] [CrossRef]
- Oleinikova, G.K.; Ivchuk, O.I.; Denisenko, V.A.; Chaikina, E.L.; Menzorova, N.I.; Nedashkovskaya, O.I.; Kuznetsova, T.A. Indolic metabolites from the new marine bacterium Roseivirga echinicomitans KMM 6058T. Chem. Nat. Compd. 2006, 42, 713–717. [Google Scholar] [CrossRef]
- Dubocovich, M.L. N-acetyltryptamine antagonizes the melatonin-induced inhibition of [3H] dopamine release from retina. Eur. J. Pharmacol. 1984, 105, 193–194. [Google Scholar] [CrossRef]
- Bai, M.; He, J.-L.; Gao, C.-H.; Xiong, F.-X.; Yang, Y.; Yang, W.-C.; Liu, Y.-H.; Zhang, W.-F. Secondary metabolites from Bacillus thuringiensis HS66. Chem. Nat. Compd. 2022, 58, 381–383. [Google Scholar] [CrossRef]
- Yeoh, C.; Rosandy, A.; Khalid, R.; Cheah, Y. Barrientosiimonas humi ethyl acetate extract exerts cytotoxicity against MCF-7 and MDA-MB-231 cells via induction of apoptosis and cell cycle arrest. Asian Pac. J. Trop. Biomed. 2022, 12, 87. [Google Scholar]
- Karanam, G.; Arumugam, M.K. Potential anticancer effects of Cyclo(-Pro-Tyr) against N-diethyl nitrosamine induced hepatocellular carcinoma in mouse through PI3K/AKT signaling. Environ. Toxicol. 2022, 37, 256–269. [Google Scholar] [CrossRef]
- Zhang, B.; Zhao, Y.; Huang, Z.; Zhang, K.; Xu, X.; Zhao, Q.; Zhang, X. A new δ-valerolactone produced by marine Streptomyces sp. YIM 13591. Nat. Prod. Res. 2022, 1–7. [Google Scholar] [CrossRef] [PubMed]
- Ren, Y.-B.; Wang, X.-W.; Bai, J.-X.; Liu, C.; Yu, S.-L.; Zhou, Y.; Lin, C.-C.; Yao, D.-H.; Huang, J.; Wang, J.-H. Three new tyrosol derivatives from Huangjing wine. J. Asian Nat. Prod. Res. 2021, 1–7. [Google Scholar] [CrossRef] [PubMed]
- Jamal, Q.; Cho, J.-Y.; Moon, J.-H.; Munir, S.; Anees, M.; Kim, K.Y. Identification for the first time of Cyclo(D-Pro-L-Leu) produced by Bacillus amyloliquefaciens Y1 as a nematocide for control of Meloidogyne incognita. Molecules 2017, 22, 1839. [Google Scholar] [CrossRef]
- Manuja, R.; Sachdeva, S.; Jain, A.; Chaudhary, J. A comprehensive review on biological activities of p-hydroxy benzoic acid and its derivatives. Int. J. Pharm. Sci. Rev. Res. 2013, 22, 109–115. [Google Scholar]
- Ferheen, S.; Akhtar, M.; Ahmed, A.N.; Anwar, M.A.; Kalhoro, M.A.; Afza, N.; Malik, A. Nematicidal potential of the Galinsoga parviflora. Pak. J. Sci. Ind. Res. Ser. B Biol. Sci. 2011, 54, 83–87. [Google Scholar]
- Aoudia, H.; Ntalli, N.; Aissani, N.; Yahiaoui-Zaidi, R.; Caboni, P. Nematotoxic phenolic compounds from Melia azedarach against Meloidogyne incognita. J. Agric. Food Chem. 2012, 60, 11675–11680. [Google Scholar] [CrossRef]
- Nguyen, D.-M.-C.; Seo, D.-J.; Kim, K.-Y.; Park, R.-D.; Kim, D.-H.; Han, Y.-S.; Kim, T.-H.; Jung, W.-J. Nematicidal activity of 3,4-dihydroxybenzoic acid purified from Terminalia nigrovenulosa bark against Meloidogyne incognita. Microb. Pathog. 2013, 59, 52–59. [Google Scholar] [CrossRef]
- Sultana, N.; Akhter, M.; Khan, R.A.; Afza, N.; Tareen, R.B.; Malik, A. Nematicidal natural products from the aerial parts of Buddleja crispa. Nat. Prod. Res. 2010, 24, 783–788. [Google Scholar] [CrossRef]
- Sultana, N.; Akhter, M.; Khatoon, Z. Nematicidal natural products from the aerial parts of Rubus niveus. Nat. Prod. Res. 2010, 24, 407–415. [Google Scholar] [CrossRef]
- Liu, M.J.; Hwang, B.-S.; Jin, C.Z.; Li, W.-J.; Park, D.J.; Seo, S.-T.; Kim, C.-J. Screening, isolation and evaluation of a nematicidal compound from actinomycetes against the pine wood nematode, Bursaphelenchus xylophilus. Pest Manag Sci. 2019, 75, 1585–1593. [Google Scholar] [CrossRef]
- Hirsch, A.M.; Valdés, M. Micromonospora: An important microbe for biomedicine and potentially for biocontrol and biofuels. Soil Biol. Biochem. 2010, 42, 536–542. [Google Scholar] [CrossRef]

| Compounds | Mortality of M. incognita (%) ± SD | ||
|---|---|---|---|
| 24 h | 48 h | 72 h | |
| (1) | 9.06 ± 2.42 | 10.05 ± 2.43 | 36.43 ± 4.89 |
| (4) | 89.68 ± 2.91 | 98.46 ± 1.43 | 100 ± 0 |
| (9) | 29.10 ± 5.15 | 30.32 ± 4.13 | 40.75 ± 5.26 |
| (10) | 22.33 ± 5.40 | 40.19 ± 4.24 | 62.10 ± 5.37 |
| Control | 0.65 ± 0.20 | 3.62 ± 0.98 | 5.59 ± 1.28 |
Publisher’s Note: MDPI stays neutral with regard to jurisdictional claims in published maps and institutional affiliations. |
© 2022 by the authors. Licensee MDPI, Basel, Switzerland. This article is an open access article distributed under the terms and conditions of the Creative Commons Attribution (CC BY) license (https://creativecommons.org/licenses/by/4.0/).
Share and Cite
Ran, Y.; Zhang, Y.; Wang, X.; Li, G. Nematicidal Metabolites from the Actinomycete Micromonospora sp. WH06. Microorganisms 2022, 10, 2274. https://doi.org/10.3390/microorganisms10112274
Ran Y, Zhang Y, Wang X, Li G. Nematicidal Metabolites from the Actinomycete Micromonospora sp. WH06. Microorganisms. 2022; 10(11):2274. https://doi.org/10.3390/microorganisms10112274
Chicago/Turabian StyleRan, Yuan, Yu Zhang, Xin Wang, and Guohong Li. 2022. "Nematicidal Metabolites from the Actinomycete Micromonospora sp. WH06" Microorganisms 10, no. 11: 2274. https://doi.org/10.3390/microorganisms10112274
APA StyleRan, Y., Zhang, Y., Wang, X., & Li, G. (2022). Nematicidal Metabolites from the Actinomycete Micromonospora sp. WH06. Microorganisms, 10(11), 2274. https://doi.org/10.3390/microorganisms10112274

